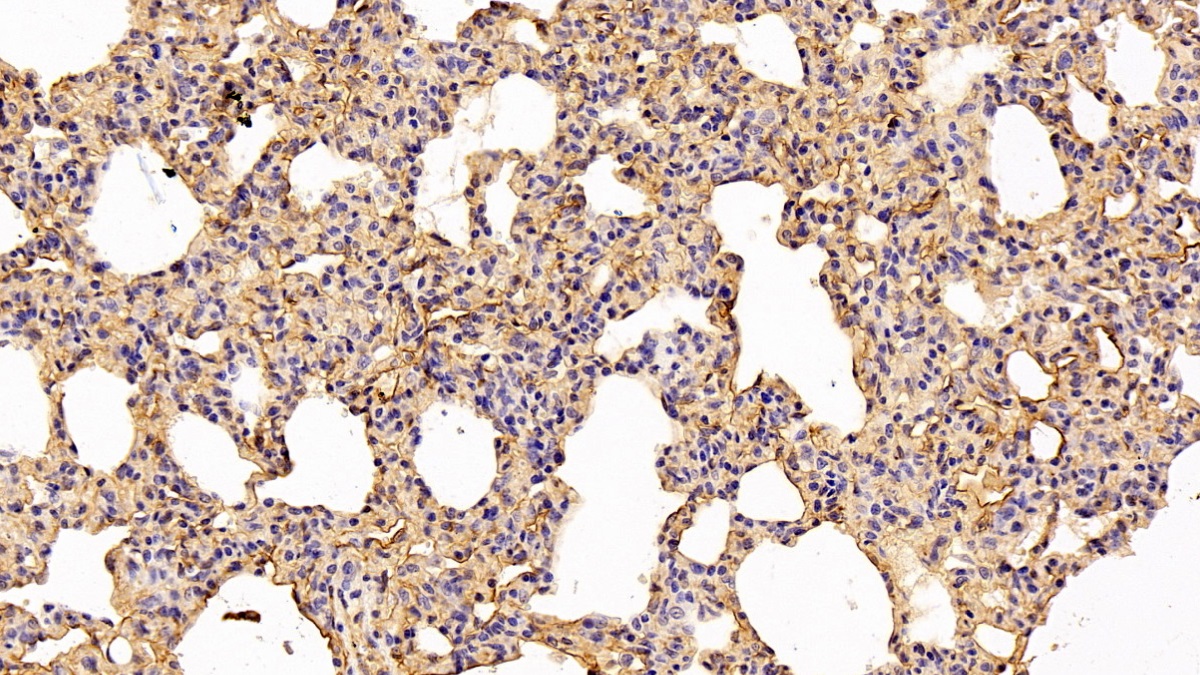

Polyclonal Antibody to Caveolin 1 (CAV1)
VIP21; Caveolae Protein 22kDa
- Product No.PAA214Hu01
- Organism SpeciesHomo sapiens (Human) Same name, Different species.
- SourcePolyclonal antibody preparation
- HostRabbit
- Potencyn/a
- Ig Type IgG
- PurificationAntigen-specific affinity chromatography followed by Protein A affinity chromatography
- LabelNone
- Immunogen RPA214Hu01-Recombinant Caveolin 1 (CAV1)
- Buffer Formulation0.01M PBS, pH7.4, containing 0.05% Proclin-300, 50% glycerol.
- TraitsLiquid
- Concentration0.5mg/ml
- Organism Species MoreMus musculus (Mouse), Sus scrofa; Porcine (Pig)
- ApplicationsWB; IHC; ICC/IF; FCM
If the antibody is used in flow cytometry, please check FCM antibodies. - DownloadInstruction Manual
- UOM 20µl100µl 200µl 1ml 10ml
- FOB
US$ 95
US$ 221
US$ 316
US$ 790
US$ 3160
For more details, please contact local distributors!
SPECIFITY
The antibody is a rabbit polyclonal antibody raised against CAV1. It has been selected for its ability to recognize CAV1 in immunohistochemical staining and western blotting.
USAGE
Western blotting: 0.03-2μg/mL;
Immunohistochemistry: 5-20μg/mL;
Flow cytometry:20μg/ml;
Optimal working dilutions must be determined by end user.
STORAGE
Store at 4°C for frequent use. Stored at -20°C in a manual defrost freezer for two year without detectable loss of activity. Avoid repeated freeze-thaw cycles.
STABILITY
The thermal stability is described by the loss rate. The loss rate was determined by accelerated thermal degradation test, that is, incubate the protein at 37°C for 48h, and no obvious degradation and precipitation were observed. The loss rate is less than 5% within the expiration date under appropriate storage condition.
GIVEAWAYS
INCREMENT SERVICES
-
 Antibody Labeling Customized Service
Antibody Labeling Customized Service
-
 Protein A/G Purification Column
Protein A/G Purification Column
-
 Staining Solution for Cells and Tissue
Staining Solution for Cells and Tissue
-
 Positive Control for Antibody
Positive Control for Antibody
-
 Tissue/Sections Customized Service
Tissue/Sections Customized Service
-
 Phosphorylated Antibody Customized Service
Phosphorylated Antibody Customized Service
-
 Western Blot (WB) Experiment Service
Western Blot (WB) Experiment Service
-
 Immunohistochemistry (IHC) Experiment Service
Immunohistochemistry (IHC) Experiment Service
-
 Immunocytochemistry (ICC) Experiment Service
Immunocytochemistry (ICC) Experiment Service
-
 Flow Cytometry (FCM) Experiment Service
Flow Cytometry (FCM) Experiment Service
-
 Immunoprecipitation (IP) Experiment Service
Immunoprecipitation (IP) Experiment Service
-
 Immunofluorescence (IF) Experiment Service
Immunofluorescence (IF) Experiment Service
-
 Buffer
Buffer
-
 DAB Chromogen Kit
DAB Chromogen Kit
-
 SABC Kit
SABC Kit
-
 Long-arm Biotin Labeling Kit
Long-arm Biotin Labeling Kit
-
 Real Time PCR Experimental Service
Real Time PCR Experimental Service
| Magazine | Citations |
| Mendel Net | Novel prostate cancer tumour markers in a cell line model Mendelu: source |
| Oncology reports | Caveolin-1 as a potential high-risk prostate cancer biomarker PubMed: 22159333 |
| Anticancer Research | Increased plasma caveolin-1 levels are associated with progression of prostate cancer among Japanese men Pubmed: 23645736 |
| Sarcoidosis Vasc Diffuse Lung Dis.? | Decrased sputum caveolin-1 is associated with systemic sclerosis related lung disease Pubmed:24751454 |
| Cancer Genomics and Proteomics | Significant Association of Caveolin-1 and Caveolin-2 with Prostate Cancer Progression PubMed: 26543085 |
| Atherosclerosis | Genomic variant in CAV1 increases susceptibility to coronary artery disease and myocardial infarction Pubmed:26775120 |
| Arthritis Research & Therapy | Increased caveolin-1 in intervertebral disc degeneration facilitates repair Pubmed:26939667 |
| Oxid Med Cell Longev | Lower Serum Caveolin-1 Is Associated with Cerebral Microbleeds in Patients with Acute Ischemic Stroke Pubmed:27119011 |
| Inflammation | Caveolin-1 Promotes the Imbalance of Th17/Treg in Patients with Chronic Obstructive PulmonaryDisease. pubmed:27613621 |
| Oxidative Medicine and Cellular Longevity | Swim Training Modulates Skeletal Muscle Energy Metabolism, Oxidative Stress, and Mitochondrial Cholesterol Content in Amyotrophic Lateral Sclerosis Mice Pubmed:29849903 |
| Microcirculation | Endothelium‐dependent hyperpolarization‐mediated vasodilatation compensates nitric oxide‐mediated endothelial dysfunction during ischemia in diabetes‐induced … Pubmed:29665152 |
| Genetic Testing and Molecular Biomarkers | The CAV1 Gene 3′ Untranslated Region Single Nucleotide Polymorphisms Are Associated with the Risk of Pulmonary Hypertension in Chinese Han Chronic … |
| Cell Rep | SIRT6 transcriptionally regulates fatty acid transport by suppressing PPAR¦Ã 34077730 |
| researchsquare | Cav-1 Protein Levels in Serum and Infarcted Brain Correlate with Hemorrhagic Volume in a Mouse Model of Thromboembolic Stroke, Independently of Rt-PA?¡ |
| Molecules | 5, 2′-Dibromo-2, 4′, 5′-trihydroxydiphenylmethanone Inhibits LPS-Induced Vascular Inflammation by Targeting the Cav1 Protein Pubmed:35566232 |
| Catalog No. | Related products for research use of Homo sapiens (Human) Organism species | Applications (RESEARCH USE ONLY!) |
| RPA214Hu01 | Recombinant Caveolin 1 (CAV1) | Positive Control; Immunogen; SDS-PAGE; WB. |
| CPA214Hu21 | OVA Conjugated Caveolin 1 (CAV1) | Immunogen; SDS-PAGE; WB. |
| PAA214Hu08 | Polyclonal Antibody to Caveolin 1 (CAV1) | WB; IHC; ICC; IP. |
| PAA214Hu01 | Polyclonal Antibody to Caveolin 1 (CAV1) | WB; IHC; ICC/IF; FCM |
| MAA214Hu22 | Monoclonal Antibody to Caveolin 1 (CAV1) | WB; IHC; ICC; IP. |
| SEA214Hu | ELISA Kit for Caveolin 1 (CAV1) | Enzyme-linked immunosorbent assay for Antigen Detection. |
| LMA214Hu | Multiplex Assay Kit for Caveolin 1 (CAV1) ,etc. by FLIA (Flow Luminescence Immunoassay) | FLIA Kit for Antigen Detection. |
| KSA214Hu01 | ELISA Kit DIY Materials for Caveolin 1 (CAV1) | Main materials for "Do It (ELISA Kit) Yourself". |